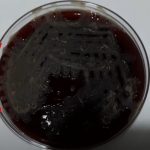
Bacillus species: Introduction, Classification and Medically Important species, Pathogenecity, Lab Diagnosis and Treatment

Tag: Bacillus
Cedecea davisae-Introduction, Morphology, Pathogenicity, Lab Diagnosis, Treatment, Prevention, and Keynotes
 Introduction of Cedecea davisae Cedecea davisae is a rare Gram-negative bacillus....
Introduction of Cedecea davisae Cedecea davisae is a rare Gram-negative bacillus....
Bacillus species: Introduction, Classification and Medically Important species, Pathogenecity, Lab Diagnosis and Treatment
Introduction Bacillus species Bacillus species are ubiquitous in nature and...
Introduction Bacillus species Bacillus species are ubiquitous in nature and...
